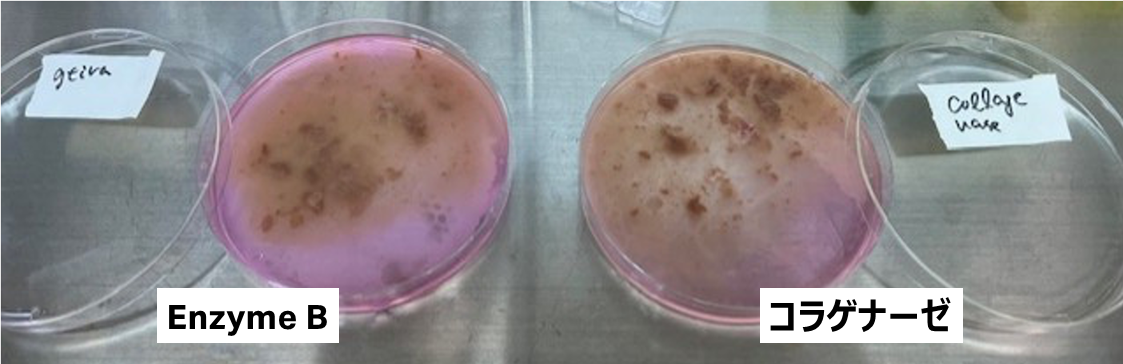
肝臓を細切し、セルストレーナーで濾過する前の写真

Dissociation enzyme B (Liver)を用いたマウス肝臓組織およびヒト肝オルガノイドのシングルセル化
11 Nov, 2025
ご協力いただいたお客様
はじめに
肝臓は肝細胞と胆管上皮細胞や血管内皮細胞などの多様な非実質細胞から構成されており、その分離は肝疾患研究や細胞機能の評価に不可欠です。さらに、多細胞を含む複雑なオルガノイドの登場からも作成されたオルガノイドの性質や薬剤への応答、標的疾患に対する細胞レベルでの表現系解析においても構成する細胞を分離することは重要です。
加えて、近年のシングルセル解析の発展により、その需要は、細胞レベルでの表現系解析だけでなく新規の機能的な細胞集団の同定や遺伝子発現制御など多岐に渡ります。一方で、肝臓の主たる構成細胞である肝細胞は、単一細胞化によるダメージで容易に細胞死が誘導されることから調整が非常に困難です。
さらに、このような細胞調整(酵素処理)によるダメージは臓器やオルガノイド内の構成細胞比率を変動させてしまうことから特にscRNA-seq、scATAC-seqなどのOmics解析において結果の解釈を大きく変えてしまうという懸念があります。そのため、単一細胞を得るための分散法および使用酵素の最適化は、適切なデータを得るうえで非常に重要な部分を占めます。
今回、Dissociation Enzyme mix B (Liver) を用いた分散法を現行法と比較検討し、その有用性を評価しました。本検討では、
- マウス肝臓組織:灌流(既存システム)・分散(Omics bundle – VIA Extractor / Dissociation Enzyme mix B)
- ヒト肝オルガノイド:マニュアル分散(Dissociation Enzyme mix B)
の2つの実験デザインを用い、Dissociation Enzyme mix B (Liver) の性能を現行法と比較評価しました。
今回の検討により、Cytiva Dissociation Enzyme mix B(Liver)は、マウス肝臓組織およびヒト肝オルガノイドの分散において、細胞生存率・純度・分離効率の面で高い性能を示し、今後のプロトコル選定において有力な選択肢となる可能性が示唆されました。
1. マウス肝臓組織の分散 – 検証デザイン
本検討では、マウス肝臓組織に対して Cytiva Dissociation Enzyme mix B (Liver) の性能を現行法(マニュアル)と比較評価しました。
評価は以下の2つのプロセスで実施しています。
- 灌流法(Perfusion)
- 組織:C57BL/6Jマウス肝臓
- 条件:門脈からのCytiva Dissociation Enzyme mix B (Liver)の灌流
- 比較対象:門脈からのコラゲナーゼ+DNaseIの灌流
- 灌流後残存組織の分散
- 組織:C57BL/6Jマウス肝臓
- 条件:VIA Extractor + Cytiva Enzyme mix B (Liver)
- 比較対象:VIA Extractor + コラゲナーゼ
このデザインにより、灌流法およびVIA Extractorを用いた分散の両方で、Dissociation Enzyme mix B (Liver) の効率や細胞回収性能を比較検討しました。
NPCおよび肝細胞回収の簡易ワークフロー – 2ステップ灌流法
(1)肝臓組織の灌流
1. 肝灌流用培地で灌流する。
2. 20 mLのコラゲナーゼ溶液 (2.5 mg Collagenase / 1.25 mg DNase I)、または 12 mLのDissociation Enzyme mix B (Liver)で灌流する。

灌流後における肝臓組織の概観写真
肝臓を細切し、セルストレーナーで濾過する前の写真
(2)肝臓組織の消化
3. 肝臓を細切し、70 μmセルストレーナーで濾過する。

70 μmセルストレーナーで濾過後の写真
4. 残存した肝組織片を、コラゲナーゼ–プロナーゼ溶液、またはCytiva Dissociation Enzyme mix B (Liver) に懸濁する。
5. Omics Bundle – VIA Extractorで処理(1バッグあたり3 mL溶液を使用)。
Homemade: 2.5 mg Collagenase / 2.5 mg Pronase / 1.25 mg DNase I in 5 mL Buffer
Cytiva: Dissociation enzyme mix B (Liver)
分散温度:37℃
処理時間:2分
処理スピード:200rpm


注:通常のマニュアル法では、酵素処理に10分要する

70 μmセルストレーナーで濾過後の写真
(1)+(2)肝臓組織の消化
6. 低速遠心により肝細胞と非実質細胞(Non-parenchymal Cells: NPCs)を分離する。
7. 溶血処理を行い、Percollを用いて死細胞を除去する。


- Cytiva Dissociation Enzyme mix B:肝細胞およびNPCsの回収率が良好
- 今回のコラゲナーゼプロトコルは、非実質細胞に対して最適な条件で行ったため肝細胞の回収率が通常よりも著しく低く、安定的な調整ができなかった。
8. 細胞をカウントし、フローサイトメトリー解析を実施(NPCのみ)
フローサイトメトリー解析結果とまとめ
- Cytiva酵素:マクロファージの回収率が良好
- 他の酵素との比較において、細胞生存率・純度・分離効率が高い傾向
- 今後のプロトコル選定において、肝臓を構成する細胞を安定的に得るための有力な選択肢となる可能性がある

2. ヒト肝オルガノイドの分散 – 検証デザイン
本検討では、ヒト肝オルガノイドに対して Cytiva Dissociation Enzyme mix B (Liver) の性能を現行のトリプシンとマニュアル分散法で比較評価しました。CDH1(E-cadherin)はヒト肝臓オルガノイドにおける上皮性細胞の指標ですが抗原が切断されやすく非常に検出が難しい抗原です。一般的にトリプシンはCDH1の細胞外ドメインを切断するため、より穏やかな細胞間接着の解離を期待してCytivaのDissociation Enzyme mix B (Liver)を検討しました。以下のワークフローで実施しています。
- Matrigelドームの解離:Dispase処理
- オルガノイドの解離:Cytiva Dissociation Enzyme mix B およびトリプシン(現行法)
- インキュベーション:37℃、15分
- 反応停止(クエンチング): 2% FBS in PBS添加
- 染色
EpCAM-FITC(1:100)
CDH1-APC(1:100)
生死判定:DAPI (1:1000) - フローサイトメトリー解析
フローサイトメトリー解析結果

※CDH1抗原が切断・損傷する可能性が示唆されたため、FCM解析でCDH1抗原を保持するためには、さらなる最適化が必要だと考えられる。

Cytiva Dissociation Enzyme mix Bはオルガノイド中のEpCAM陽性の肝細胞と胆管上皮細胞に適用可能で、オルガノイド由来細胞の生存率がより良好であった。
細胞生存率: 2.5 g/L Trypsin (51.0%), Dissociation enzyme mix B (82.0%)
EpCAM陽性細胞: 2.5 g/L Trypsin (10.3%), Dissociation enzyme mix B (23.3%)
本検討のまとめ(Cytiva Dissociation Enzyme B)
マウス肝臓(灌流・消化)
- 他の酵素との比較において、細胞生存率・純度・分離効率が高い傾向
- コラゲナーゼによる現行法と遜色のない細胞生存率
- マクロファージ回収効率が高い
ヒト肝臓オルガノイド
- Trypsinと比較して高い細胞生存率を示した。
- EpCAM陽性の肝細胞および胆管細胞の高効率での回収に有効
- CDH1抗原の切断・損傷の可能性があり、最適化が必要